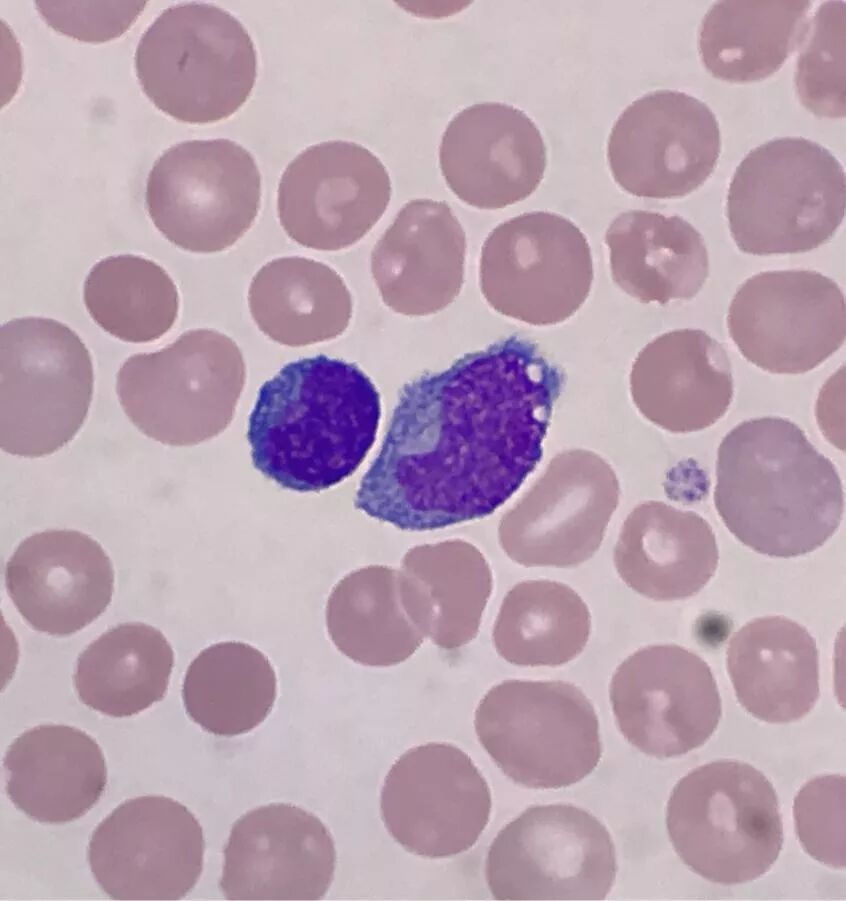
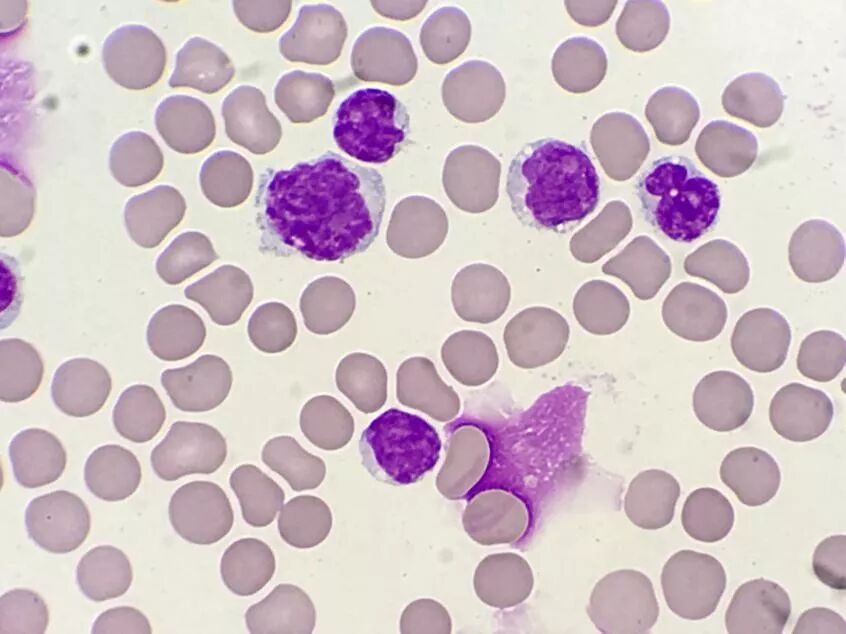
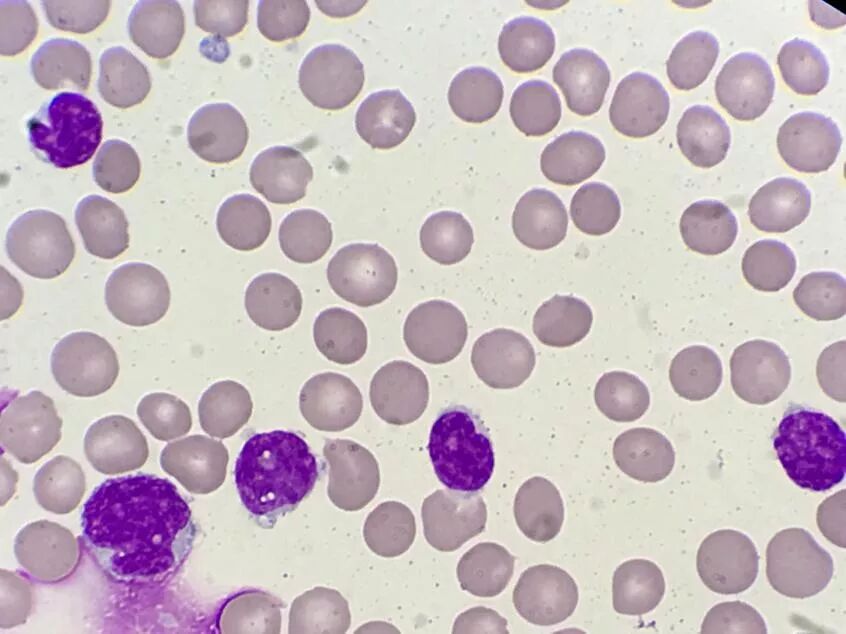

作者 | 胡艳,周霞,黄俊
单位 | 成都市第三人民医院临床医学检验部
前 言
细胞形态学检验是通过显微镜发现和辨别细胞形态等有形成分质和量的改变。将分析结果提供给临床,辅助临床对相关疾病的诊断、愈后判断及治疗方案的探讨都具有重要的意义。
案例经过
患者,男,61岁,因“口干、多饮、消瘦1月+双下肢水肿1周”入院,内分泌科就诊,随后转诊血液科治疗。
主要临床表现:乏力、消瘦、上腹部不适、多尿、大便次数增多等。
查体:颈部、腹股沟等处多个表浅淋巴结扪及肿大。
影像学检查:双侧胸腔积液、腹腔积液、肝脾肿大。
入院初步诊断:1.消瘦待诊
2.淋巴结肿大待诊
3.软组织挫伤
案例分析
实验室检查
肝功能:TBIL 38.44 umol/L↑
TP 59.5 g/L↓
ALB 22.6 g/L↓
AST 86.6 U/L↑
ALT 28.0 U/L
ALP 295.1 U/L↑
LDH-L 359.6↑
肿瘤标志物:CA125 620.70 U/ml↑
NSE 32.30 ng/ml↑
Ferr 462.80 ng/ml↑
血常规:WBC 27.99×109 /L
RBC 3.11×1012 /L
HGB 108 g/L
PLT 42×109 /L
白细胞手工分类:淋巴细胞 74.0%
中性粒细胞 13.0%
杆状细胞 3.0%
单核细胞 1.0%
嗜酸性粒细胞 1.0%
嗜碱性粒细胞 1.0%
中性中幼粒细胞 1.0%
中性晚幼粒细胞 3%
异常细胞 3.0%
建议做进一步检查。
血常规散点图如下所示:散点图提示异常淋巴细胞/原始细胞?未成熟粒细胞?血小板减少

外周血涂片如图所示:(瑞氏染色×1000)

骨髓穿刺结果增生极度活跃:淋巴细胞61.5%,以成熟小淋巴细胞为主。CLL/SLL?

外周血流式细胞分型结论:B细胞淋巴瘤侵犯外周血

融合基因检测结论:CCND1/IGH融合基因阳性

胸水生化检查总蛋白 25.2 g/L
LDH 375.4 U/L
ADA 23.6 U/L
胸水常规检查性状:红色、浑浊
浆膜黏液蛋白定性试验:阳性
细胞总数计数:190440×106 /L
有核细胞计数:18440×106 L
胸水涂片如图所示:(瑞氏染色×1000)

形态描述:涂片查见异常细胞,该类细胞胞体中等大小,胞浆量少,染淡蓝色,胞核偏大,核染色质较细致、畸形,胞核、胞浆均可见空泡样改变,结合病史及基因分型,考虑该类异常细胞为套细胞淋巴瘤可能。
病理诊断报告结论(胸水):部分细胞异型,建议免组协诊。

病理诊断报告结论(淋巴结):淋巴组织增生性病变/肿瘤,建议免组协诊。

最后诊断:1.套细胞淋巴瘤IV期B组8分高危组
2.化疗后骨髓抑制
3.胸腔积液
治疗方案本病例目前确诊为套细胞淋巴瘤,根据病情予以R-CHOP方案化疗。患者持续出现血小板减少、贫血症状,避免重要脏器出血风险,给予输血治疗;低白蛋白,给予人血白蛋白对症治疗;胸腔积液,采取闭式引流,目前患者病情较好转。
总 结
套细胞淋巴瘤(mantlecelllymphoma,MCL)是一类比较少见的B细胞侵袭性非霍奇金淋巴瘤[1]。中位发病年龄约60岁,男性高于女性。
MCL兼具侵袭性淋巴瘤的侵袭性和惰性淋巴瘤的不可治愈性[1],80%以上的患者诊断时处于疾病晚期(AnnArbor分期Ⅲ~Ⅳ期)[2],常伴结外器官侵犯,如胃肠道、骨髓和外周血浸润,部分患者淋巴细胞明显增多,有类似慢性淋巴细胞白血病(CLL)表现;流式细胞检测显示几乎所有患者均有外周血/骨髓受累。
特征性标志为细胞遗传学t(11;14)(q13;q32)异常导致的细胞周期蛋白(Cyclin)D1核内高表达,该类型约占总数的95%[2];免疫组化显示B细胞抗原(+),并且以CD5、cyclinDl和SOX11(+)[1]。
淋巴瘤侵犯胸膜较常见,由于胸膜下区有丰富的淋巴管和淋巴集合体,淋巴瘤胸膜侵润时,淋巴管以及静脉阻塞导致胸腔出现血性积液。有的时候可能被误诊为恶性肿瘤的胸腹膜转移或者是结核性多发性浆膜腔炎症。
本病例胸腔积液中查见淋巴瘤样细胞,结合临床表现、血形态学、骨髓诊断、流式细胞分型以及融合基因诊断等,考虑套细胞淋巴瘤侵犯可胸膜可能。但在临床工作中,若已确诊为淋巴瘤的患者,其体液标本的细胞学检验中,检出异常幼稚淋巴细胞可作出符合性诊断。
参考文献
[1]梅开勇.套细胞淋巴瘤临床病理特征及免疫表型分析[J].诊断病理学杂志,2013(5):275-278.
[2]顾康生.2018淋巴瘤年度回顾|套细胞淋巴瘤回顾与展望[N].中国医学论坛报,2019-02-01.

—END—说明:本文为原创投稿,不代表国际检验医学传媒、检验医学微信平台观点。转载时请注明来源及原创作者姓名和单位。
编辑:徐少卿 审校:陈雪礼


我就知道你在看!